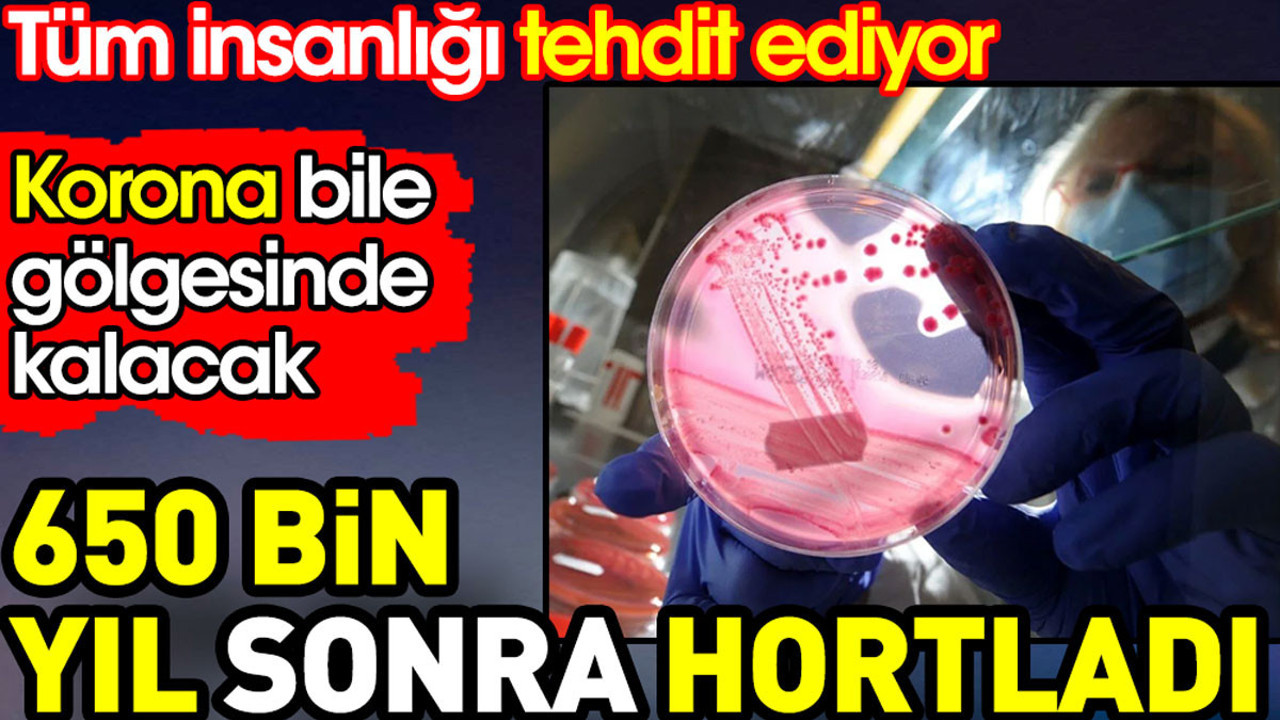
650 bin yıl sonra hortladı, insanlığı tehdit ediyor. Korona bile gölgesinde kalacak

Bilim insanları, dünya ısınmaya devam ettikçe onlarca, yüzyıllar, hatta yüz bin yıllar boyunca uykuda kalan donmuş bir dizi ölümcül hastalığın ortaya çıkmasından korkuyor.
650 BİN YIL SONRA ORTAYA ÇIKIYOR
Yapılan araştırmalarda, bilim insanları öldürücü bir 'Faktör X' virüsünün yaklaşık 650 bin yıldır Dünya'nın donmuş tabakasında gizlenip, küresel ısınmayla birlikte ortaya çıkabileceği konusunda tüm insanlığı uyardı.
Daha da kötüsü, gezegen ısınmaya devam ettikçe iklim değişikliğinin yüz binlerce yıldır uykuda olan bir dizi ölümcül hastalığın geri gelmesine neden olacağı belirtiliyor.
Bu duruma sebep olan şeyin ise, donmuş toprağın (permafrost) çok sayıda uyku halindeki mikrobiyal türe ev sahipliği yapması olarak açıklandı.
Uzmanlar, bunun aynı zamanda çiçek hastalığı veya bir zamanlar atalarımızı kasıp kavuran patojenler gibi soyu tükenmiş hastalıkların salınmasını da tetikleyebileceği konusunda uyarıyor.
Newsweek’te yer alan makalede, İsveç'teki Umea Üniversitesi'nde bulaşıcı hastalıklar profesörü Birgitta Evengard, hakkında çok az şey bilinen bir "Faktör X" virüsünün olduğunu söylüyor.
Aix-Marseille Üniversitesi'nden virolog Jean-Michel Claverie'ye göre, Neandertalleri veya mamutları enfekte eden ve bunların yok olmasına neden olan eski virüslerin de bu donmuş toprakların içinde yer alması mümkün olabilir.
Donmuş toprakların içerisinde neler olabileceği konusunda konuşan Claverie, ‘‘Çiçek hastalığı gibi soyu tükenmiş hastalıklardan kaynaklanan virüsler; sporla kontamine olmuş alanlarda her zaman mevcut olan şarbon; ve ayrıca tularemi, ciddi bir bakteriyel enfeksiyon veya kene kaynaklı ensefalit gibi günümüzün Kuzey Kutbu'nda zaten var olduğu bilinen hastalıklar burada saklanıyor olabilir’’ dedi.
ISINMAYLA BİRLİKTE BAŞKA VİRÜSLER DE ORTAYA ÇIKMIŞTI
2016 yılında Sibirya'daki bir sıcak hava dalgası, 12 yaşında bir çocuğu ve binlerce hayvanı öldüren ölümcül şarbon sporlarını harekete geçirmişti.
Uzmanlar, kuzey yarımkürenin dörtte birinin permafrost tabakasının üzerinde bulunduğunu tahmin ediyor, ancak dünya ısındıkça geniş alanlar artık eriyor.
Gezegen halihazırda sanayi öncesi dönemlere göre 1,2 santigrat derece daha sıcak ve bilim insanları Kuzey Kutbu'nun 2030'larda buzsuz yazlar görebileceği konusunda uyardılar.
PERMAFROST NEDİR?
Permafrost; Alaska, Sibirya ve Kanada gibi Arktik bölgelerde bulunan, Dünya yüzeyinin altında kalıcı olarak donmuş bir tabakadır.
Genellikle buzla birbirine bağlanmış toprak, çakıl ve kumdan oluşur ve en az iki yıl boyunca sıcaklığı 0°C'nin altında kalan zemin olarak sınıflandırılır.
Dünyanın donmuş topraklarında 1.500 milyar ton karbonun depolandığı tahmin ediliyor; bu, atmosferde bulunan miktarın iki katından fazla.
Eğer küresel ısınma dünyadaki donmuş toprakları eritecek olsaydı, atmosfere binlerce ton karbondioksit ve metan salabilirdi.
Bazı permafrost bölgeleri, binlerce yıldır donmuş halde kaldığından bilim insanları için özellikle ilgi çekicidir.
Permafrostta bulunan antik kalıntılar şimdiye kadar bulunanların en eksiksizleri arasında yer alıyor çünkü buz, organik maddenin ayrışmasını engelliyor.
İskitler olarak bilinen bir grup göçebe tarafından Sibirya'da gömülen 2 bin 500 yıllık cesetler, dövmeli derileri hala sağlam halde bulundu.
2010 yılında Rusya'nın Arktik kıyısında ortaya çıkarılan bir yavru mamut cesedi, 39 bin yıldan daha eski olmasına rağmen hala saç kümelerini taşıyordu.
Permafrost aynı zamanda Dünya'nın jeolojik tarihinin incelenmesinde de kullanılıyor, çünkü binlerce yıl boyunca Arktik bölgelerin derinliklerinde gömülü olan toprak ve mineraller bugün kazıp incelenebiliyor.
CİVA, NÜKLEER ATIK VE BOMBA SERPİNTİSİ
Üstelik buzulların erimesi sadece oradaki virüsleri de açığa çıkarmakla kalmayacak. Konuyla ilgili açıklama yapan araştırmacılara göre, sivrisinek ve kene gibi böcekler daha kuzeye göç etmeye devam edecek ve potansiyel olarak bu eski virüslerle temasa geçecek. Böylece eski virüsle buluşan bu hayvanlar insanlığı daha büyük bir tehdide sürükleyecek. Araştırmacılar bunun en kötü senaryo olduğunu dile getirdi.
Bir diğer kötü senaryo da buzullarda bulunan civa, nükleer atık be bombalardan kalan ağır metaller olarak gösterildi. Bunların hepsi, donmuş toprakta kilitli olan ve permafrost çözüldükçe karbondioksit olarak açığa çıkacak olan 1.700 milyar ton karbon havayoluyla tüm insanlığı tehdit edecek.